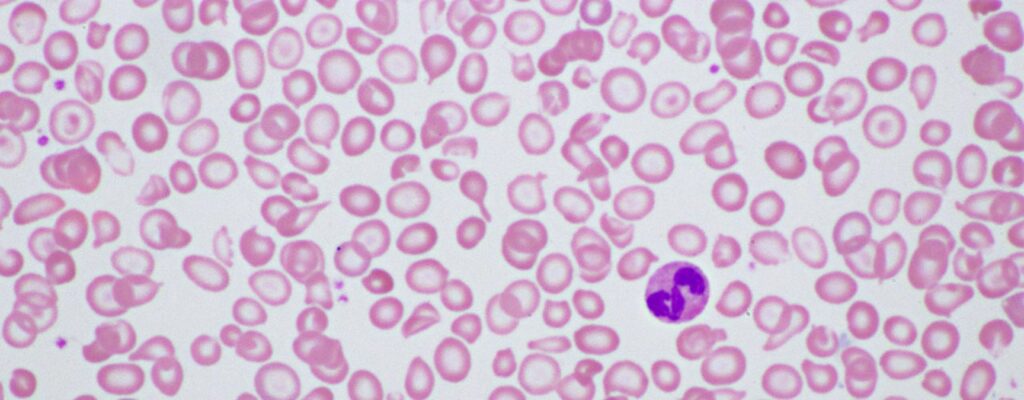
can cord blood cure thalassemia

News
News

Filter:

Can You Use Tea Tree Oil While Pregnant?
The hormone shifts that come with pregnancy can bring issues like acne with it. Many women try to opt for

Is Cinnamon Safe During Pregnancy?
Cinnamon, derived from the dried bark of Cinnamomum trees, has been used for centuries in traditional medicine and cuisine across

Can I Drink Black Tea While Pregnant?
Pregnancy brings lots of questions about what’s safe to drink, and black tea is a common one. It’s a flavorful,

Can You Take Melatonin While Pregnant?
Sleep problems are incredibly common during pregnancy. Hormonal shifts, physical discomfort, anxiety, and frequent nighttime awakenings can all make restful

What to Eat Before Induction: Best Foods + What to Avoid
If you have a scheduled induction coming up, it’s completely normal to feel a mix of anticipation, nerves, and logistical

Pelvic Pain During Pregnancy: PGP & SPD Explained
Pregnancy reshapes your body in ways that are both extraordinary and demanding. As your baby grows, your posture shifts, your

How Much Tylenol Can I Take While Pregnant?

How Long Does Induction Take? First & Second-Time Moms

Clary Sage for Labor: Does It Work? + How to Use It

Red Raspberry Leaf Tea for Pregnancy and Labor

High Fiber Foods for Constipation During Pregnancy

Are Bananas Good for Pregnancy? Benefits & When to Avoid

7 Signs You’re Dilating: How to Know & How to Check

What Is a Membrane Sweep? Pros, Cons + What to Expect

Is Peppermint Oil Safe During Pregnancy?

Beef Liver Supplements During Pregnancy: Are They Safe?

Can You Drink Kombucha While Pregnant?

Liquid I.V. During Pregnancy: What You Need to Know

7 Glucose Test Alternatives (More Natural, Less Invasive)

Foley Balloon Induction: Benefits, Risks, & How Long It Takes

Okra Water for Pregnancy: Benefits, Risks, & Recipes
Can Cord Blood Cure Thalassemia?

Does Curb Walking Actually Help Induce Labor?

Prodromal Labor: Symptoms, Causes & How Long It Lasts
